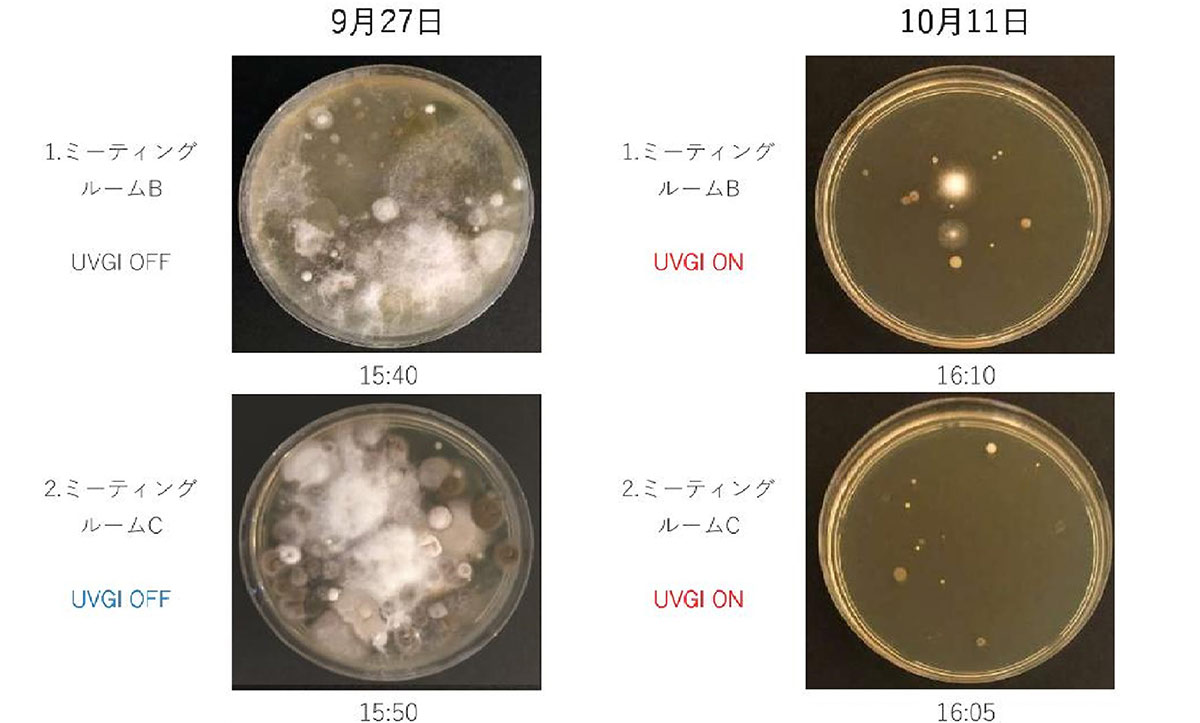

GLIPミーティングルームで浮遊菌を退治せよ!
2022.02.21

TOKYO GLIP Office General Manager
大場 壹朧
GLIPの全体統括。自らの起業経験を活かし、
積極的にaxle御茶ノ水に入居するベンチャー企業とも交流。
GLIPの顔として日々フットワーク軽く活動している。
GLIPの全体統括。自らの起業経験を活かし、
積極的にaxle御茶ノ水に入居するベンチャー企業とも交流。
GLIPの顔として日々フットワーク軽く活動している。
いきなり、なに?浮遊菌の退治に参加せよっていう意味?とか言われそうなタイトルで始まりました。
皆さんこんにちは!いやいや、決してお遊びではないので変なタイトルをお許し下さい。何でこのようなタイトルにしたかというと、GLIPのミーティングルームの浮遊菌を退治するために選んで設置した「エアシールド」というマシーンの威力が凄くて、まさに「浮遊菌退治!」なんです。これを皆さんにお伝えしたかったのです。

この「エアシールド」、マシーンと表現していながらも、その大きさはティッシュの箱の大きさぐらいです。その雑菌の詳細はといいますと、紫外線照射で浮遊雑菌をやっつけるということらしいのです。写真を見る限り、本当にただのティッシュの箱みたいなものです。これが正に強力!
もう一つの写真をご覧下さい。(この写真、ちょっとグロテスクなので、ご自身で加減してご覧下さい。)少し前にミーティングルームに設置したエアロシールドですが、設置前後の検査結果が出ました。
写真は、9月27日設置時のサンプル採集→10月11日設置後でエアロシールド稼働2週間後のサンプル採集を示しています。大変興味深い結果でした。
簡単に見る方法は、浮遊菌サンプル最終したシャーレーの写真です。左の2つが右の2つに菌の数が減ったということです。
「UVGI OFF」と「UVGI ON」とは、エアシールドのOFFとONのことです。つまり、ONにして2週間後にはこれ程の効果が表れているのです。
「これ程」という表現は曖昧でありますので数値で説明しますと(表をご覧下さい。)、ミーティングルームBではエアロシールド設置前は浮遊菌の数は564/m2→設置後は48/m2、ミーティングルームCではエアロシールド設置前は浮遊菌の数は424/m2→設置後は44/m2と効果が出ております。

なんと、設置後は浮遊菌の数は80%~90%の減少だそうです。エアシールド恐るべし!です。
このエアロシールド、ご注意頂きたい点が一つあります。設置について、床より2.4mの高さに取り付けてあり、そこから90度で照射しています。正面からエアシールドをのぞき込むと紫外線による目への影響があるとのことで、のぞき込んだり皮膚に直接当てたりしないようにとされています。
これは何でも興味津々のGLIPメンバーには、よく言って聞かせておかないと、その構造を知りたいがためにのぞき込むどころかマシン内部を開けてしまったりしちゃいますから、目が離せないったらなりません。(笑)
このエアロシールドの効果を知り、現在はミーティングルームのみに設置しておりますが、GLIP全体に設置する方向で社内検討しています。私達GLIPではコロナ対策としてアルコール消毒やアクリルパネルなどで従業員を守っておりますが、目に見えない浮遊菌に対しても対策をしております。
冒頭に私が書きました、「GLIPのミーティングルームの浮遊菌を退治するために選んで設置したエアシールドというマシーンの威力が凄くて、まさに浮遊菌退治!なんです。」って文章ですが、嘘じゃないでしょ?!



ピックアップ

YouTubeチャンネル
新着動画
トヨタコネクティッド本社を訪問した、小林可夢偉選手から新たな挑戦をする人へのメッセージをいただきました。











